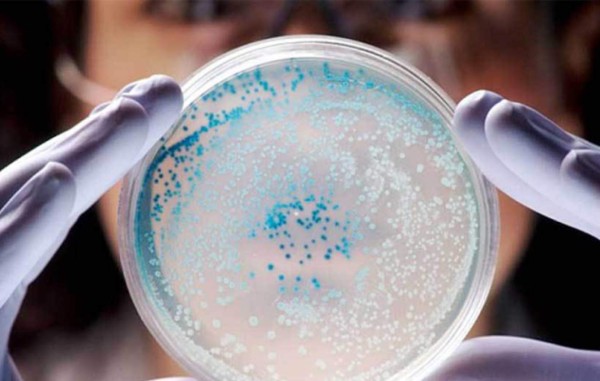
Muere una tercera persona en EUA por bacteria comecarne

Una tercera persona falleció en Florida, EUA, debido a una peligrosa bacteria que vive en el agua marina y devora la carne, lo que aumenta a trece la cifra de infectados, confirmó hoy el Departamento de Salud de este estado.
Las autoridades sanitarias informaron que el fallecimiento se registró en el condado de Sarasota, al sur de Tampa, como consecuencia de la bacteria 'Vibrio Vulnificus', que pertenece a la familia del germen que causa el cólera, habita en el agua marina y es propensa a reproducirse en agua salobre caliente.
En Florida se ha reportado la muerte de dos personas a causa de esta bacteria, una de ellas residente en el condado de Dixie, en la costa noroeste, y la otra en Lee, en la costa suroeste del estado.
La 'Vibrio Vulnificus' puede penetrar en el cuerpo a través de una herida o cortes en la piel y suele afectar de manera especial a personas mayores con problemas en su sistema inmunológico.
También se puede contraer al ingerir marisco crudo, especialmente ostras, y los síntomas más comunes son diarrea, vómitos y dolor abdominal. Es necesario tratarla con antibióticos.
Esta bacteria logra 'invadir el torrente sanguíneo, ocasionar fiebre, bajada de la presión sanguínea, úlceras en la piel' y, en el 50 por ciento de los casos, puede resultar 'fatal', agregaron las autoridades sanitarias.

Entre 1988 y 2006, el Centro para el Control y Prevención de Enfermedades (CDC) contabilizó en los estados de la costa del Golfo más de 900 casos de infecciones por esta bacteria.
En 2013, 41 personas resultaron infectadas en Florida y 11 de ellas fallecieron.
Según la base de datos a la que tuvo acceso Efe, en 2008 se registraron 15 casos de infectados y 5 fallecidos; en 2009, 24 infectados y 7 muertos; en 2010, 32 infectados y 10 muertos; en 2011, 35 infectados y 13 muertos; y en 2012, 27 infectados y 9 muertos. EFE